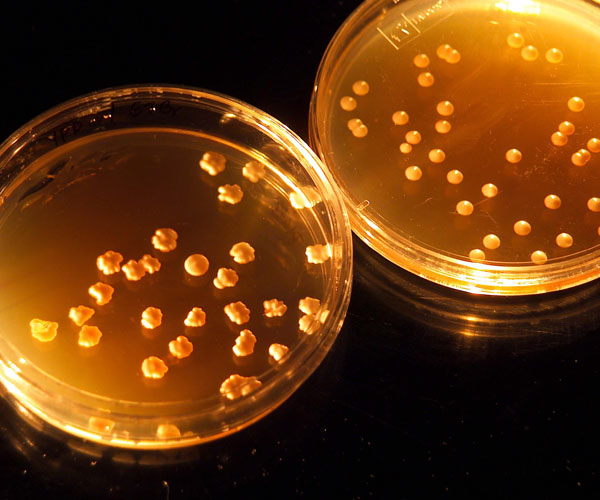

Διαβάστε το νέο τεύχος των Αναλέκτων εδώ Το πόσες διαδρομές μπορεί να ακολουθήσει ο ανθρώπινος νους στο άκουσμα του θέματος που πραγματεύεται το 21ο τεύχος των Αναλέκτων είναι κάτι που μπορεί κανείς να φαντάζεται, αλλά δύσκολο να καταγράψει. Προφανώς η προστασία του περιβάλλοντος, του κοινού σπιτιού όλων των φυλών του κόσμου, είναι μια αναγκαιότητα στην οποία κανείς δεν εναντιώνεται, τουλάχιστον φραστικά. Και επίσης προφανώς όταν μιλάμε για την κλιματική αλλαγή το πέρασμα από τα λόγια στην πράξη γίνεται ακόμα μια αναγκαιότητα και μάλιστα επιτακτική. Κάπως έτσι βρίσκεται το αυτοκίνητο με τα προφανή καυσαέριά του στο μάτι του κυκλώνα, με τεράστιες αυτοκινητοβιομηχανίες να απασχολούν δεκάδες χιλιάδες επιστήμονες υψηλής ειδίκευσης στην προσπάθειά τους να μειώσουν σε ελαχιστότατα επίπεδα τις εκπομπές ρύπων, ικανοποιώντας τις ολοένα ...